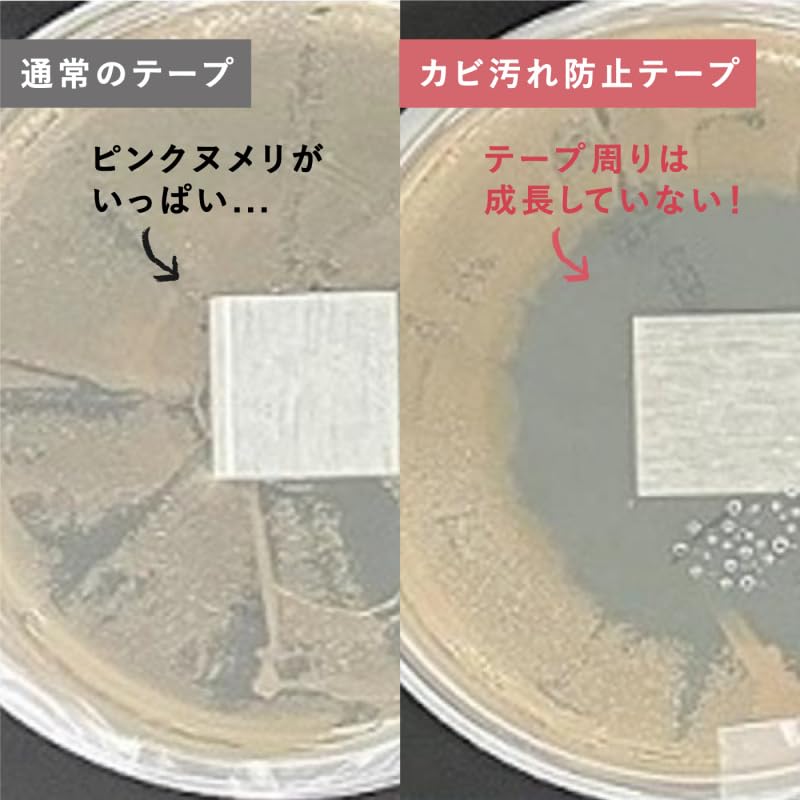
Mt Schimmel- und Fleckenprävention Weiß Breit Abdeckband Breit für und Schärband, (30mm / 3er-Pack) - Wasserfestes Klebeband, (Wasserfest/schmutzabweisend),

Dein Browser unterstützt die Seite nicht. Bitte aktualisiere deinen Browser oder lade einen anderen herunter
Mt Schimmel- und Fleckenprävention Weiß Breit Abdeckband Breit für und Schärband, (30mm / 3er-Pack) - Wasserfestes Klebeband, (Wasserfest/schmutzabweisend),
Aktueller Preis
Preis 51,38 €inklusive MwSt.
Lieferung innerhalb von 🇩🇪 Deutschland
13–21 Werktage · 4 € pro Bestellung
Sichere Zahlungen und Datenschutz







Sicherheit & Konformität
Beschreibung
SAKURA J-Happy Selection
5/3
Ähnliche Produkte

![KAWAGUCHI TK94016 Klebeband für 20 mm 20 m lang aus wasserabweisenden doppelseitigen Stoffen, breit, [Set 3]](https://img.joomcdn.net/d9aba5bd652a4090e05d884e0a6c1e0096c4f168_82_100.jpeg)

















